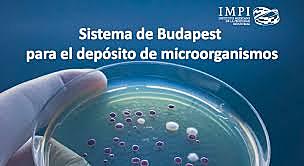
Tratado de Budapest

-
Fue concedida a Filippo Brunelleschi, en Florencia.
-
La ley de patentes de Venecia, es claramente medieval porque corresponde con las políticas económicas adoptadas por los poderes públicos en la Edad Media para proteger y fomentar la tecnología, respondiendo a la idea liminar de que su bienestar y progreso material es directamente proporcional al fracaso de su rival en el comercio internacional.
-
Este Estatuto de Monopolios concedía exclusividad solamente al verdadero y primer inventor de invenciones nuevas por un período máximo de 14 años.
-
Se concedió a la demandante el "derecho y la libertad de hacer, construir, utilizar y expendedora a otros única y exclusiva que se utilizarán" de su invención.
-
-
Titulado Convenio de París para la Protección de la Propiedad Industrial
-
Establece el “derecho de prioridad”. En el ámbito de las patentes, aquella persona que haya presentado una primera solicitud de patente en alguno de los Estados Contratantes, goza de un derecho de prioridad en caso de presentar otra solicitud relativa a la misma invención en cualquiera de los demás Estados Contratantes durante un período de 12 meses, contados a partir de la fecha de presentación de la primera solicitud.
-
Es el instrumento internacional más antiguo del campo del derecho de autor.
Trata: De la protección de las Obras y derechos de los autores, ofrece a estos los medios para controlar quién usa su obras, cómo y en qué condiciones.
Ligar: Berna, Suiza. -
El sistema permite proteger una marca en gran número de países mediante la obtención de un registro internacional que surte efecto en cada una de las Partes Contratantes que hayan sido designadas.
-
Es una solución centralizada que permite a los titulares de marcas obtener y mantener la protección en múltiples mercados.
El Sistema de Madrid ofrece varias ventajas a los titulares de marcas. -
El termino existe desde hace tiempo y ya se mencionaba su represión como una de las formas de proteger la propiedad intelectual en la revisión de Bruselas de 1900 del Convenio de París.
-
Protección de los artistas intérpretes o ejecutantes, los productores de fonogramas y los organismos de radiodifusión.
-
Es una organización intergubernamental con sede en Ginebra. La UPOV fue constituida por el Convenio Internacional para la Protección de las Obtenciones Vegetales. A partir de ese momento comenzaron a reconocerse en todo el mundo los derechos de propiedad intelectual de los obtentores sobre sus variedades.
La misión de la UPOV es proporcionar y fomentar un sistema eficaz para la protección de las variedades vegetales con miras al desarrollo de obtenciones vegetales en beneficio de la sociedad. -
Menciona: “todos los demás derechos relativos a la actividad intelectual en los terrenos industrial, científico, literario y artístico”
Lugar: Estocolmo , Suecia -
-
El PCT establece un procedimiento simplificado para que el inventor o el solicitante soliciten, y posteriormente obtengan, patentes en un gran número de países.
El objetivo principal del PCT es simplificar y hacer más eficaces y económicos los métodos anteriores o tradicionales de presentación de solicitudes para la protección de patentes de invenciones en varios países, en interés de los usuarios del sistema de patentes y de las oficinas encargadas de administrar dicho sistema. -
El Convenio de Berna rige la protección del derecho de autor y en él se sientan principios como el trato nacional, que dice que la legislación nacional no puede discriminar a las obras de otros países que son parte en el Convenio.
Lugar: París, Francia. -
Sobre el Reconocimiento Internacional del Depósito de Microorganismos a los fines del Procedimiento en materia de Patentes.
-
El sistema permite proteger una marca en gran número de países mediante la obtención de un registro internacional que surte efecto en cada una de las Partes Contratantes que hayan sido designadas.
-
Es uno de los convenios emanados de las negociaciones comerciales de la Ronda Uruguay y que administra la Organización Mundial del Comercio.
-
tiene como objetivo armonizar y agilizar los procedimientos nacionales y regionales de registro de marcas mediante la simplificación y la unificación de determinados aspectos de esos procedimientos
-
-
Dicho tratado respondió a la necesidad de proteger las obras que se transmiten por el medio digital, particularmente por la vía de Internet.
-
Este tratado tiene por objeto ofrecer una mayor protección de los derechos patrimoniales y morales de los artistas intérpretes o ejecutantes y los productores de fonogramas (artículos 5 a 10 del WPPT), sobre todo en lo que respecta a su ejercicio en el entorno digital, en particular en Internet.
Lugar: Ginebra -
-
Este tratado tiene por objeto ofrecer una mayor protección de los derechos patrimoniales y morales de los artistas intérpretes o ejecutantes y los productores de fonogramas (artículos 5 a 10 del WPPT), sobre todo en lo que respecta a su ejercicio en el entorno digital, en particular en Internet.
-
Tiene en cuenta la evolución más reciente en el ámbito de las tecnologías de la comunicación.
Es el primer instrumento internacional sobre derecho de marcas que reconoce expresamente las marcas no tradicionales, como los hologramas o las marcas tridimensionales, de color, de posición, animadas o sonoras. -
Es el tratado multilateral más reciente que se ocupa de los derechos conexos, este tratado protege los derechos conexos de los artistas intérpretes o ejecutantes sobre las obras audiovisuales, (entrará en vigor cuando haya 30 Partes Contratantes).
-
Es el tratado multilateral de derecho de autor mas novedoso.
Es un tratado de naturaleza humanitaria porque se crea un conjunto de limitaciones y excepciones obligatorias del derecho de autor en beneficio de las personas ciegas, con discapacidad visual y otras dificultades para acceder al texto impreso.
Lugar: Marrakech, Marruecos. -
Con el fin de mejorar y actualizar el Arreglo de Lisboa.
Dicha Acta contempla el registro internacional de indicaciones geográficas, además del de denominaciones de origen. -
versa sobre la incidencia de la protección de las obtenciones vegetales en Viet Nam